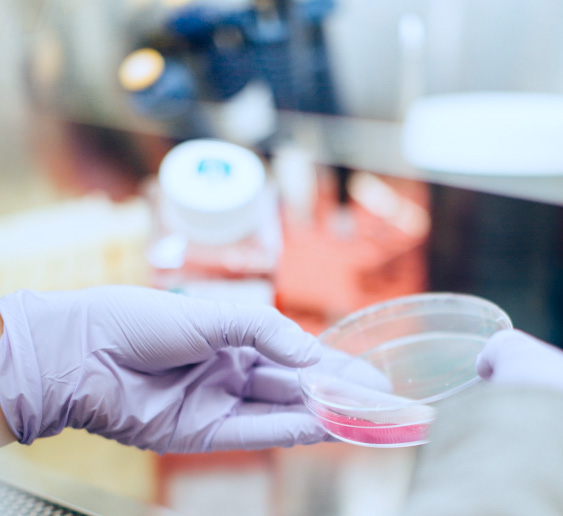

Active pharmaceutical ingredients (APIs) are the components of a pharmaceutical drug that produce the required effect on the body to treat a condition. Global Pharma Tek is a pharmaceutical company that supplies top-tier APIs with high-quality standards.